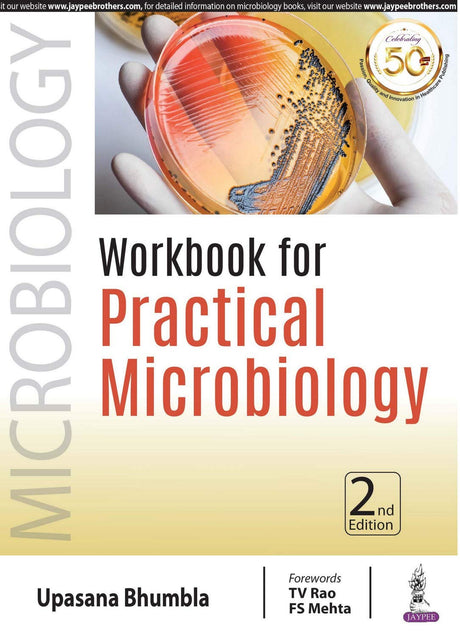

Jaypee Brothers Medical Publishers
Sale price Rs.3,619.00 Regular price Rs.4,825.00Unit price /UnavailableJaypee Brothers Medical Publishers
MEDICAL MICROBIOLOGY MADE EASY
Sale price Rs.845.00 Regular price Rs.1,125.00Unit price /UnavailableCBSPD
ESSENTIALS OF MICROBIOLOGY 2ED (PB 2018)
Sale price Rs.750.00 Regular price Rs.995.00Unit price /UnavailableWiley
Karps Cell Biology 8Ed Global Edition (Pb 2018)
Sale price Rs.3,409.00 Regular price Rs.4,485.00Unit price /UnavailableOxford University Press, USA
Sale price Rs.10,551.00 Regular price Rs.14,988.00Unit price /Unavailable- 24% offNew arrival
PEARSON EDUCATION
MICROBIOLOGY: A LABORATORY MANUAL, 11TH EDN, GLOBAL EDITION
Sale price Rs.5,755.00 Regular price Rs.7,553.00Unit price /Unavailable Jaypee Brothers Medical Publishers
WORKBOOK FOR PRACTICAL MICROBIOLOGY
Sale price Rs.640.00 Regular price Rs.850.00Unit price /UnavailableElsevier
Medical Microbiology International Edi
Sale price Rs.2,691.00 Regular price Rs.3,767.00Unit price /UnavailableElsevier
Microbiology Practical Manual, 1e
Sale price Rs.480.00 Regular price Rs.685.00Unit price /UnavailableCBSPD
ATLAS OF MEDICAL MYCOLOGY (PB 2019)
Sale price Rs.475.00 Regular price Rs.595.00Unit price /Unavailable- 25% offNew arrival
Paras Medical Publishers
Essentials of Microbiology & Immunology : Through Questions & Answers 1st Ed 2019
Sale price Rs.825.00 Regular price Rs.1,095.00Unit price /Unavailable Elsevier
Sale price Rs.707.00 Regular price Rs.1,010.00Unit price /UnavailableCBS
THE CELL 2 VOL SET (PB 2020): Two-Volume Set
Sale price Rs.1,346.00 Regular price Rs.1,795.00Unit price /UnavailableCBSPD
PRAKASHS NOTEBOOK OF MICROBIOLOGY INCLUDING PARASIOLOGY AND ENTOMOLOGY 3ED (PB 2020)
Sale price Rs.940.00 Regular price Rs.1,250.00Unit price /UnavailableJaypee Brothers Medical Publishers
SYSTEMIC FUNGAL INFECTIONS: PRINCIPLES, PATHOGENESIS & PRACTICE
Sale price Rs.5,269.00 Regular price Rs.7,025.00Unit price /Unavailable- 20% off
CBSPD
COVID 19 CHALLENGES AHEAD (PB 2020)
Sale price Rs.360.00 Regular price Rs.450.00Unit price /Unavailable